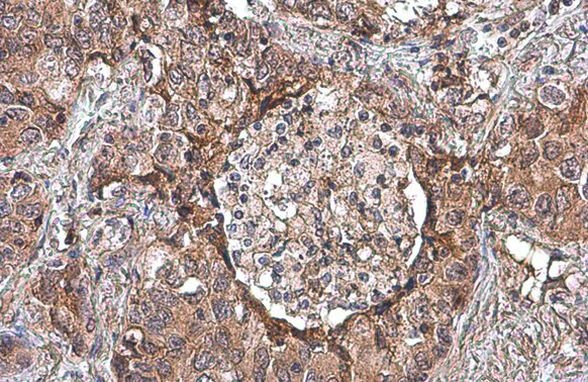
Uteroglobin Antibody in Immunohistochemistry (Paraffin) (IHC (P))

Search
Invitrogen
Uteroglobin Polyclonal Antibody
{{$productOrderCtrl.translations['antibody.pdp.commerceCard.promotion.promotions']}}
{{$productOrderCtrl.translations['antibody.pdp.commerceCard.promotion.viewpromo']}}
{{$productOrderCtrl.translations['antibody.pdp.commerceCard.promotion.promocode']}}: {{promo.promoCode}} {{promo.promoTitle}} {{promo.promoDescription}}. {{$productOrderCtrl.translations['antibody.pdp.commerceCard.promotion.learnmore']}}
图: 1 / 5
Uteroglobin Antibody (PA5-78215) in IHC (P)





产品信息
PA5-78215
种属反应
宿主/亚型
分类
类型
抗原
偶联物
形式
浓度
规格
纯化类型
保存液
内含物
保存条件
运输条件
RRID
产品详细信息
Positive Control: human lung, rat lung
Store product as a concentrated solution. Centrifuge briefly prior to opening the vial.
靶标信息
Uteroglobin, which is a member of the Secretoglobin superfamily and is also known as Clara cell phospholipid-binding protein, is a multifunctional protein that can exert anti-inflammatory and anti-tumorigenic effects by binding small hydrophobic molecules such as phospholipids and prostaglandins. The small, non-glycosylated protein named for its high levels of expression in pre-implantation embryos, where it exhibits growth stimulatory effects, is produced and secreted by the non-ciliated, non-mucous Clara cells predominant in the epithelial surfaces of pulmonary airways, as well as other non-ciliated epithelia. Members of the Secretoglobin superfamily demonstrate a high level of structural conservation and are characterized as small, secretory homo- or heterodimers. In addition to sequestering pro-inflammatory mediators and carcinogens, Uteroglobin has been implicated in the inhibition of cell migration and invasion, platelet aggregation, and T cell differentiation.
仅用于科研。不用于诊断过程。未经明确授权不得转售。
篇参考文献 (0)
生物信息学
蛋白别名: Blastokinin; CC10; CCPBP; clara cell 17 kDa protein; clara cell phospholipid-binding protein; clara cell secretory protein; clara cells 10 kDa secretory protein; club cell 10 kDa secretory protein; Club cell 17 kDa protein; Club cell phospholipid-binding protein; club cell protein 16; Club cells 10 kDa secretory protein; club secretory protein 16; PCB-binding protein; SCGB1A1; Secretoglobin family 1A member 1; secretoglobin family 1A member 1 (uteroglobin) isoform SCGB1A1_1; secretoglobin family 1A member 1 (uteroglobin) isoform SCGB1A1_2; secretoglobin, family 1A, member 1 (uteroglobin); unnamed protein product; UP-1; Urinary protein 1; urine protein 1; Uteroglobin; Uteroglobin (Clara cell secretory protein); Uteroglobin (club-cell specific 10-kD protein)
基因别名: CC10; CC16; CCPBP; CCSP; PCB-BP; PCBB; SCGB1A1; UG; UGB; UP-1; UP1; Utg
UniProt ID: (Human) P11684, (Mouse) Q06318, (Rat) P17559
Entrez Gene ID: (Human) 7356, (Mouse) 22287, (Rat) 25575